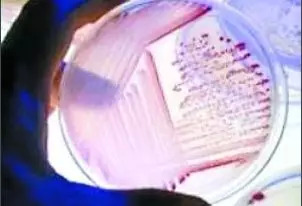

文|差评
美国东部时间的 5 月 2 日,一个名为 Beyond Meat 的公司在纳斯达克声势浩大上市了,市值一度突破了十亿美元大关。

而给它站台的人里,有好几个异常响亮的名字—— 比尔 · 盖茨、埃文·威廉姆斯( Twitter 现任 CEO )、多恩·汤普森( 前麦当劳 CEO )、雷昂纳多 · 迪卡普里奥( 演员小李子 )。。。
如此豪华的明星背书阵容,以及在美股新晋成员中鹤立鸡群的股价数据,让人不禁想发问:“ 这位 Beyond Meat 到底是哪位互联网界新秀贵族? ”
IPO 当天,Beyond Meat 股价涨了 163%,数据甚至燃起了人们对经济形势的新希望。

事实上,Beyond Meat 既不是什么手上攥了上亿粉丝流量的社交媒体公司;也不是什么日活千万,拥有八、九位数用户的明星科技产品。恰恰相反,它来自一个离互联网界有点领域 —— 食品行业。
而它专注的,正是目前很热门的 ——人造肉。
emmmm,当然,这里小辣椒说的不是我们常常能吃到的豆腐混合压制,就想蒙混过关的素鸡。
虽然这种以前小学门口五毛钱一包的素肉零食是真的好吃。。。
但我们今天要讨论的,是真正可以以假乱真的 “ 鲜肉 ”!
能看出哪块真,哪块儿假吗

2009 年,Beyond Meat 公司正式成立,但关于纯植物的仿真肉研究,早在公司成立之前的近十年就已经开始了。
来自密苏里大学的两个教授,先是花了十年时间泡在实验室里,做什么呢?提炼豆子的蛋白质。。。
他们的目标是做出可以仿真鸡肉的植物蛋白!在此之后,他们和 Beyond Meat 的总裁伊森 · 布朗合作, 又花了快五年的时间推出了第一个产品 —— 仿真鸡肉。
2012 年,第一个产品问世

仿真鸡肉的面世,引来了社会各界不小的关注,根据媒体的报道,经过烹饪加工过后,吃起来连美食家都分不出来它和真鸡肉的区别。
可问题也还是明显存在,“ 假鸡肉 ” 的热量比真肉更低,营养价值也变少了,价格也比真实的鸡肉贵了一些,平均每 9 盎司( 约合半斤 )仿真鸡肉差不多 50 多人民币。
不过瞅瞅这质地,小辣椒看着完全 OK 的啊!

在第一次的鸡肉尝试之后,Beyond Meat 之后相继推出了牛肉、猪肉等各种肉类,甚至推出了主打新品 The Beyond Burger( 超越堡 )。

这生意是越做越大了。。。
亚马逊上100 块左右一磅的价格完全可以接受

看到这里,差友们肯定很好奇一个问题:这些仿真肉都是怎么做出来的?真的安全吗?
我们先来说做法:
目前科学界主流的人造肉方法其实只是只有两种,一个是是动物干细胞培育,在实验室中让一块肉自己 “ 长 ” 出来;
另一个是从植物中提取蛋白质,加工成口感、味道都接近真实的肉类的仿真品。
干细胞培育

Beyond Meat 公司为了追求纯素食肉类,当然选择的是第二种方法( 小辣椒觉得很可能是因为成本比第一种方法低太多…… )。

提取蛋白,重组食物纤维,加入植物血红素,最后是注入灵魂 —— 很多很多植物油。
这样,一块儿一放在锅子上就会 “ 滋滋滋 ” 响的汉堡肉就大功告成啦!

至于安全性,就目前来说只要整个培育实验的环境和过程足够清洁、干净就不会有什么问题,毕竟,吃的蛋白质还是那些蛋白质,并没有什么变化。

相比于安全性,小辣椒觉得多样性才是我最担心的。。。目前提取蛋白的方法做出来的人造肉,只能做碎肉,不能做整整块儿的牛排,很大程度上限制了烹饪方式。
干细胞培养的方法虽然可以很大程度上解决这个问题,但是是真的贵啊。。。要一斤完整的肉,成本也就 4、5 万软妹币吧。
干细胞培育出来的肉是一条一条的,需要拼接堆叠在一起。
成本高、肉类单一,比起更健康、热量更低的优点,人造肉的问题貌似多了去了,为什么 Beyond Meat 的仿真肉还能得到这么多大佬的青睐?
当然是因为。。。人类对于肉食的痴迷啦!素食主义者终于也能放心吃肉了!
就单单在美国,素主义者就占了近总人口的 4%,而这部分人放弃食肉其实大多数都并不是因为讨厌肉的味道,而是出于健康、动物保护和环保( 降低畜牧业对全球变暖造成的影响 )的原因,也就是说,要是两全能其美,何乐而不为?
这好几千万人的庞大商业市场,不抢还是人呐?

在食品行业,研究一种新的菜系,调制出一种全新的口味是再普通不过的操作,而创造一种新的食材却一点也不常见。。。
在我们传统概念里,人造的一定没有天然的绿色、健康,人类似乎天生对 “ 人工 ” 有一种抵触情绪。
但随着科技的进步,更多的不可能成为可能,小辣椒相信人造肉也有广泛被大众接受的一天,emmmmm,只要好吃不贵健康,啥都好说啊。
参考资料:
《人造肉公司BeyondMeat受到投资市场追捧》,煎蛋
维基百科:超越肉类公司
YouTube 视频:Heme - The Magic Ingredient in the Impossible Burger


评论